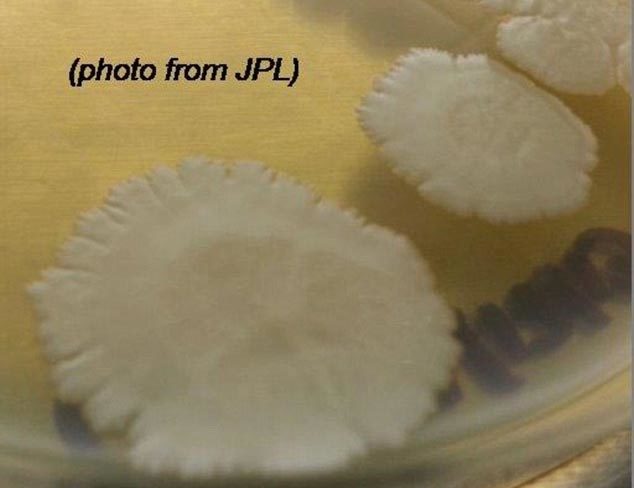
{keywords}

Bộ sưu tập gồm 48 chủng vi khuẩn vô hại, đang được cất giữ trong phòng thí nghiệm của Trạm vũ trụ quốc tế (ISS) đã khiến các nhà khoa học ngạc nhiên thích thú. Họ phát hiện, những vi sinh vật này dường như không chỉ điều chỉnh để thích nghi với cuộc sống trong môi trường vi trọng lực, mà một trong số chúng còn tỏ ra thích thú với nó hơn môi trường trên Trái đất.
Trong vũ trụ, một chủng vi khuẩn được thu thập ở bang Florida, Mỹ đã phát triển tốt hơn tới 60% so với các nhóm cá thể cùng loài được theo dõi trên Trái đất. Tại sao lại có hiện tượng này vẫn là bí ẩn đối với các nhà nghiên cứu.
Chủng vi khuẩn nói trên có tên gọi là Bacillus safensis JPL-MERTA-8-2. Theo một nghiên cứu đăng tải trên tạp chí PeerJ, B. safensis được phát hiện lần đầu tiên trên một trong các tàu thám hiểm sao Hỏa tại Trung tâm vũ trụ Kennedy năm 2004.
Các chuyên gia rất quan tâm tới sự thích nghi của các vi khuẩn trong vũ trụ, vì họ muốn hiểu rõ cách các vi khuẩn Trái đất vô tình được đưa vào không gian có thể đe dọa sức khỏe của các nhà du hành vũ trụ như thế nào trong các sứ mệnh dài ngày tương lai và thậm chí có thể bám trụ trên Mặt trăng hay sao Hỏa ra sao.
Trong một thử nghiệm quốc tế ký hiệu là Dự án MERCURRI, các nhà khoa học đã thu thập các mẫu vi khuẩn từ nhiều bề mặt khác nhau, kể cả từ Chuông tự do ở Philadelphia, bang Pennsylvania và từ nơi tổ chức các sự kiện thể thao có nhiều người tham gia trên khắp nước Mỹ. Để tránh rủi ro, bộ sưu tập vi khuẩn khổng lồ sau đó đã được thu hẹp xuống chỉ còn 48 chủng vi khuẩn không gây bệnh và được đưa lên trạm ISS vào ngày 19/4/2014. Một bộ sưu tập giống hệt được nuôi giữ đối chiếu trong một phòng thí nghiệm trên Trái đất.
Cứ mỗi 24 tiếng đồng hồ, các mẫu lại được các nhà du hành vũ trụ cũng như chuyên viên phòng thí nghiệm kiểm tra một lần trong suốt 4 ngày. Tháng 2/2015, các mẫu trên vũ trụ được gửi trả về Trái đất và chuyển cho Đại học California (Mỹ) để phân tích.
Nhà vi trùng học David Coil, người đứng đầu dự án MERCURRI, cho biết, trong vũ trụ, hầu hết các vi khuẩn không hành xử khác biệt so với trên Trái đất. Song, ông Coil và các cộng sự nhận thấy, 3 trong số 48 mẫu vi khuẩn cho thấy sự tăng tốc phát triển trong điều kiện vi trọng lực, nhưng 2 trong số chúng được xác định là do bị nhiễm bẩn.
Chỉ mình chủng B. safensis JPL-MERTA-8-2 được công nhận phát triển tốt hơn trong không gian. Các nhà nghiên cứu vẫn chưa rõ tại sao lại như vậy.
Tiến sĩ Coil tin rằng, trọng lực khó có khả năng gây ra khác biệt lớn đối với từng cá thể vi khuẩn, vì chúng quá nhỏ bé. Tuy nhiên, nó có thể ảnh hưởng đến các cộng đồng vi khuẩn. Chuyên gia này cho rằng, việc nghiên cứu kỹ lưỡng hơn về Bacillus safensis có thể dẫn tới những hiểu biết thú vị về lí do tại sao chủng này lại sinh trưởng mạnh hơn đến như vậy trong môi trường vi trọng lực.
Tuấn Anh (Theo Daily Mail)
XEM THÊM CÁC TIN CÔNG NGHỆ MỚI NHẤT: